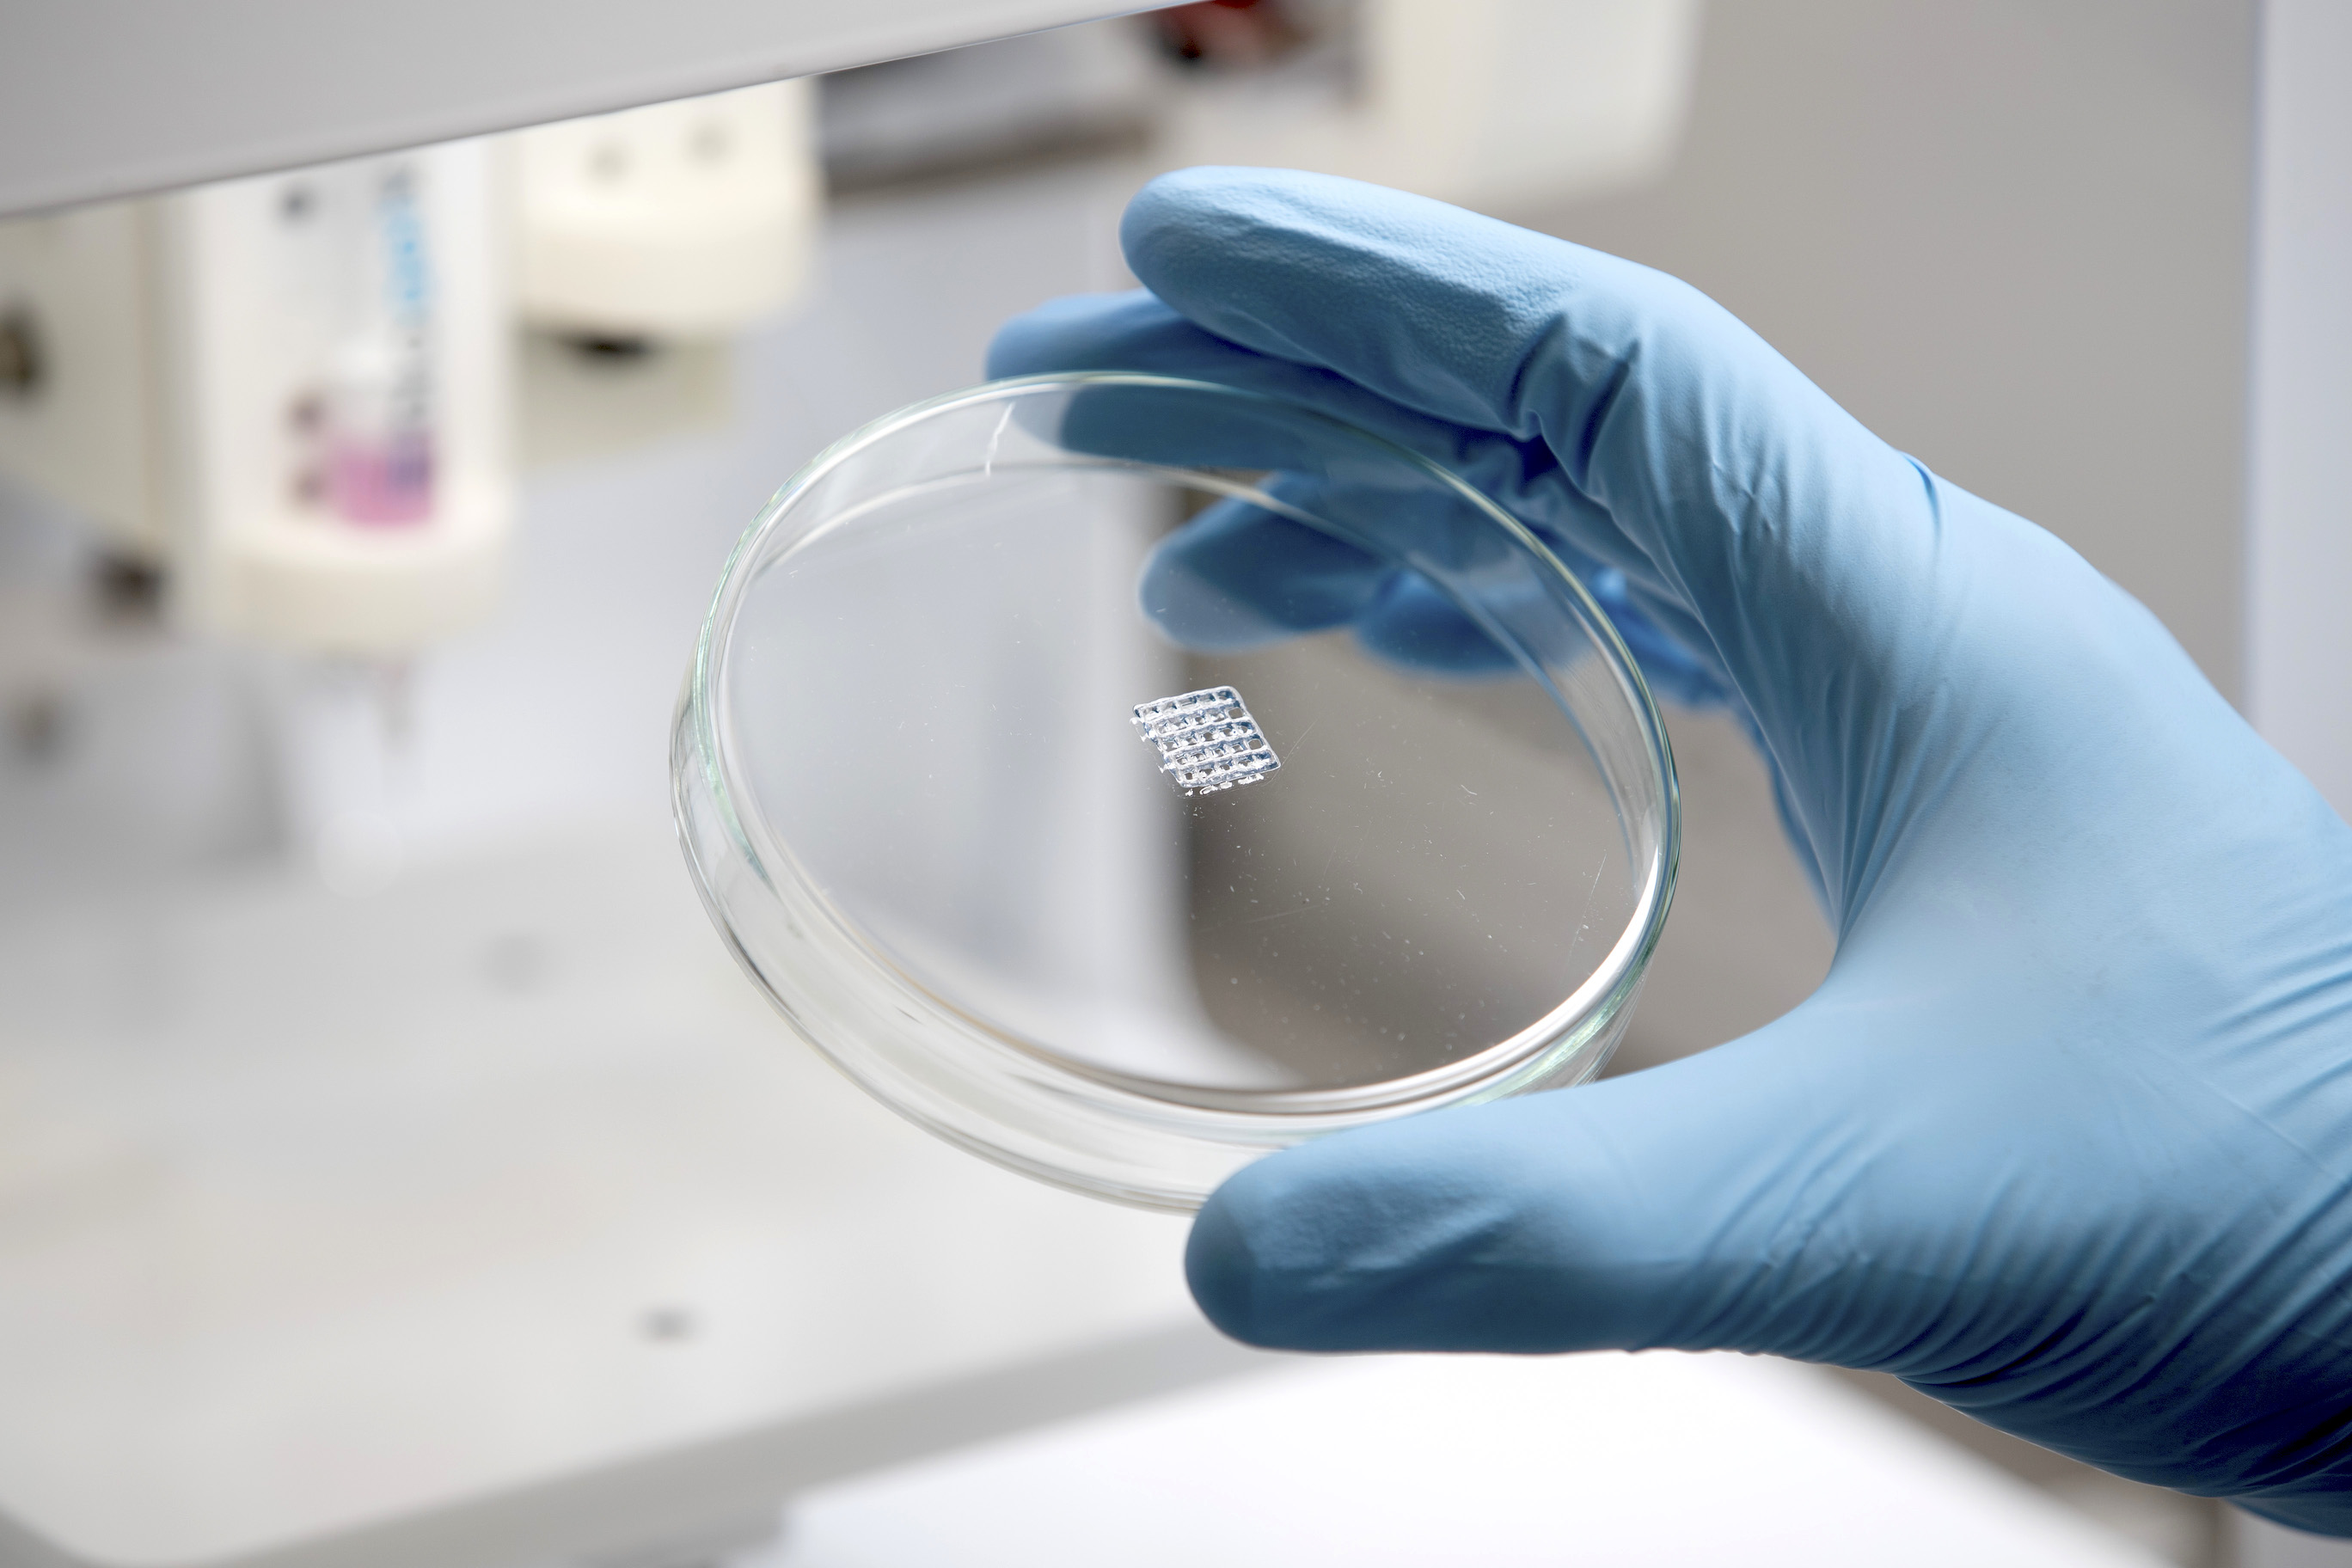
A sample of 3D printed Biogelx™-INK. Photo via Biogelx

A 3D printed tumour designed and fabricated by 3D LifePrints, a UK-based medical technology company, has aided surgeons in the removal of a cancerous mass in six-year-old, Leah Bennett.
Bennett was admitted to Alder Hey Children’s Hospital in Liverpool after experiencing back pain. Various scans and tests lead to the diagnosis of a large unknown tumour at the bottom of her spine. Additive manufacturing was implemented to establish the optimal approach to extract 90% of the malignancy. Paul Fotheringham, Founder of 3D LifePrints stated:
“We are immensely proud to have been able to positively contribute to Leah’s battle with cancer. The biomedical engineers in our embedded 3D printing hub were able to prepare a detailed 3D model for this timely case over the weekend to help the surgical team at Alder Hey plan Leah’s ‘impossible’ surgery. This case perfectly illustrates the value of combining innovation and technology at the point of care.”

3D printing guides high-risk surgery
According to the medical team at Alder Hey, Bennett’s tumour was located close proximity to a number of important anatomical regions including the spinal cord and superior mesenteric artery. It was also observed to be enveloping large portions of vessels such as the aorta and inferior vena cava.
Several medical institutions aware of her case advised against surgery due to the high risk of life-threatening blood loss. Moreover, nine rounds of chemotherapy were seen to be unsuccessful. Therefore, the medical team sought out their in-house Innovation Hub, led by Iain Hennessey, a Surgeon and Clinical Director of Innovation and 3D LifePrints, who have been embedded within Alder Hey for around five years.

The road to recovery
A 3D printed model of the tumour and surrounding anatomical areas was created for presurgical planning, thus increasing the chances of safe and effective removal. 3D LifePrints’ biomedical engineers utilized the patient’s CT scan data detailing the anatomy and tumour and fabricated a model using Stratasys 3D printing technology.
David Collins, Biomedical Engineer, 3D LifePrints, added, “Working closely with the surgeons, we completely understood how urgent this case was and how imperative accuracy would be, given the odds. Their faith in us came from our longstanding relationships in the hospital and over the course of a weekend we were able to ready the model for delivery for the multidisciplinary team meeting in which the go-ahead for surgery would be made.”
Following almost seven weeks of radiotherapy, Bennett has made a steady recovery. Donations are presently being raised for the multiple charities that supported her treatments. Click here to find out more.

Nominations for the 2020 3D Printing Industry Awards are now open. Have your say of who the leaders in the industry are.
Keep up to date with industry-relevant financial reports this season by subscribing to the 3D Printing Industry newsletter, following us on Twitter and liking us on Facebook.
Seeking jobs in engineering? Make your profile on 3D Printing Jobs, or advertise to find experts in your area.
Featured image shows the 3D printed tumour model. Photo via 3D LifePrints.
UPM, a Finnish alternative energy and material company, has launched a range of bioinks known as GrowInk, designed for various 3D bioprinting applications such as tissue engineering and regenerative medicine.
The GrowInk range features novel non-animal derived hydrogels that emulate the in vivo environment to support cell growth and differentiation. The materials debuted at the SLAS2020 science conference in San Diego, California.

Eco-friendly 3D bioprinting materials
Founded in 1996, UPM develops and supplies sustainable wood-based biomedical products. Its GrowDex line includes hydrogels for 3D cell culturing and research. In 2018, the company released a recyclable biocomposite filament for FDM 3D printers, UPM Formi 3D, which uses cellulose fibers and biopolymers. Last year, the biotechnology company and it’s subsidiary, UPM Biocomposites, as well as robotics manufacturer ABB and Prenta Oy, collaborated to create large components and furniture using its recyclable UPM Formi filament.
According to UPM, the two main components of its latest bioinks, GrowInk, are its nanofibrillar cellulose and water. This is integrated to provide a defined matrix that can be directly mixed with cells and customized. A sterile hydrogel known as GrowDex-A has also been introduced. This hydrogel is designed to bind biotinylated molecules including proteins, peptides, and antibiotics for 3D cell culture.

GrowInks for medical research
Presently, the GrowInk materials are available in three variations. The first, GrowInk-N is a natural opaque bioink made of pure nanofibrillar cellulose. GrowInk-T, a transparent, anionic nanofibrillar cellulose bioink for advanced applications that can be optionally cross-linked to harden printed structures. Finally, GrowInk-ALG a nanofibrillar cellulose-based bioink with alginate that can be cross-linked.
Nominations for the 2020 3D Printing Industry Awards are now open. Vote for who you think has made the biggest impact in the medical sector.
Stay updated with additive manufacturing news by subscribing to the 3D Printing Industry newsletter, following us on Twitter and liking us on Facebook. Seeking jobs in engineering? Make your profile on 3D Printing Jobs, or advertise to find experts in your area.
Featured image shows GrowInk 3D bioprinting materials. Photo via UPM.
Walmart has partnered with SmileDirectClub, a Nashville-based teledentistry company that uses 3D printing to make aligners, to exclusively offer its line of oral care products.
The news, announced on January 6th, was well received by the stock market as trading raised SmileDirectClub’s stock price (NASDAQ: SDC) by 21% three days prior.
Then on January 14th, SmileDirectClub announced the distribution of its clear aligner solutions through a wholesale channel via dentists and orthodontists in-office. Taking the gain from 21% to 34%. This follows the expiration of the company’s supply agreement with Align Technology Inc, the Californian company behind Invisalign which ended on December 31, 2019.
During this period shares of Align Technologies fell by approximately 3%. The overall increase in the stock price during this announcement period (January 3rd-15th) stood at 63.72%. The SmileDirectClubs stock price has now closed at $13.69.
Alex Fenkell, a co-founder of SmileDirectClub, stated, “We’re excited to expand our offering and welcome new providers to add an important and needed offering to their suite of services.”
“We have seen increasing demand from the dentists and orthodontists in our network who wish to provide SmileDirectClub clear aligners to their in-office patients, and with our agreement with Align Technology now expired, we are no longer obligated to stay in the direct-to-consumer channel.”

A clearly aligned path
Founded in 2014, SmileDirectClub creates personalized clear aligners in collaboration with its digital network of state-licensed dentists and orthodontists. The company has said to have helped over 750,000 people correct their smiles through remote doctor-directed clear aligner therapy, whereas Align Technology has states that it has treated more than 2.5 million patients with Invisalign in over 45 countries.
In 2016, Align Technologies entered into a supply agreement to manufacture for SmileDirectClub which saw the company acquire a 17% stake in SmileDirectClub for $46.7 million. This is no longer upheld and the two companies are now in direct competition.
Last year, at RAPID + TCT, SmileDirectClub announced a partnership with HP to increase the production of its clear aligners with the deployment of 49 Multi Jet Fusion systems at the company’s Antioch, Tennessee facility. SmileDirectClub claims that this is the “largest 3D printing facility in the United States,” unfortunately the claim is not supported by facts whether defined by the number of printers, floor space or output.
That’s not to say the volumes involved are not impressive. The Antioch factory produces more than 50,000 unique 3D printed mouth molds a day. In contrast, Joseph Hogan, CEO of Align Technology, has stated that over 500,000 unique 3D printed parts for Invisalign clear aligners are produced per day using 3D Systems technology.

Opening a new dental network
SmileDirectClub’s retail debut through Walmart will see its line of oral care products available at all U.S locations as well as its online store. The range includes an electric toothbrush ($24.98), a teeth whitening system complete with LED light ($39.98), toothpaste, a water flosser, and a UV cleaner that sanitizes toothbrush heads, aligners, retainers, and dentures. This launch intends to support consumers in tandem with the teeth-straightening process.
According to Dr. Jeffrey Sulitzer, SmileDirectClub Chief Clinical Officer, within the estimated figure of 200,000 licensed dentists and orthodontists in the U.S, only an estimated 30% offer clear aligner therapy in their offices. Therefore, opening a network to these providers would enable more customized and affordable patients treatment plans. Most recently, the company came under criticism after it asked unsatisfied customers to sign restrictive nondisclosure agreements (NDAs) that stop them from expressing any negative opinions or reviews on SmileDirectClub, according to The New York Times.
In the continuing theme of competitor comparison, it has received over 1670 Better Business Bureau complaints since 2014, while Align Technology has received five since 2000, The New York Times article states. This may have some questioning the quality of services and products from an open dental network from fresher companies.

Subscribe to our 3D Printing Industry newsletter and follow us on Facebook and Twitter for more additive manufacturing news. Also, visit our 3D Printing Jobs board to find out more about opportunities in additive manufacturing.
Featured image shows personalized clear aligners. Photo via SmileDirectClub.
Denise Vicentin, a Brazilian cancer survivor who lost her right eye and part of her jaw, has received a facial prosthesis develop using a 3D printed prototype.
Researchers at Paulista University (UNIP), São Paulo, Brazil, implemented its method, published in the Journal of Otolaryngology – Head & Neck Surgery, which uses a smartphone to capture digital facial impressions of patients with maxillofacial defects. This data is then used to create cost-effective additively manufactured facial prostheses.
“In the past, it took much longer work, hours of sculpting by hand, and the process was very invasive, with material on the patient’s face to get an imprint of their appearance,” explained Rodrigo Salazar, the lead researcher, and UNIP Postgraduate Dental School.

A maxillofacial 3D printed prosthesis
Vicentin, 53, was diagnosed with a facial tumor 30 years ago. It was then removed twice but returned in a malignant form 20 years later. As a result of her previous treatment, she has difficulty eating and her speech is slurred. In 2018, Luciano Dib, supervisor of the study and UNIP Postgraduate Dental School, began developing the prosthesis method after seeing 3D printing used at a mall.
Shortly after, Dib started working with Vicentin to produce a personalized prosthesis. Thus, she underwent multiple surgeries to build up her facial tissue. Dib then implanted titanium rods in her eye socket to holds the prosthesis. The researchers took 15 pictures of Vicentin’s face from various angles, which were used to make the 3D model.
A 3D printed prototype prosthesis was then used to create the final device in 12 hours -which was produced from silicone, resin, and synthetic fibers. This was then painted to match Vicentin’s skin and eye color.

Treating facial defects with additive manufacturing
Upon the success of Vicentin’s prosthesis, Dib and Salazar plan to open a treatment center for facial prosthetic rehabilitation built by UNIP in 2021. As stated by the researchers, creating a prothesis for Vicentin using conventional techniques would involve equipment costing up to $500,000. Their method requires a computer and a smartphone.
Elsewhere, companies are also advancing maxillofacial implants and prostheses that integrate additive manufacturing. Previously, Latvian 3D software company, WiDE, received a CE mark for its software that helps users to quickly iterate 3D printed prosthesis in new sizes. Moreover, the Québec Industrial Research Centre (CRIQ), installed a GE Additive Arcam Electron Beam Melting (EBM) Q10 Plus machine at its facility to accelerate the development of patient-specific lower jawbone implants.
The UNIP study, “Monoscopic photogrammetry to obtain 3D models by a mobile device: a method for making facial prostheses” is co-authored by Rodrigo Salazar-Gamarra, Rosemary Seelaus, Jorge Vicente Lopes da Silva, Airton Moreira da Silva, and Luciano Lauria Dib.
Stay updated with the latest in additive manufacturing by subscribing to the 3D Printing Industry newsletter. Also, follow us on Twitter, and like us on Facebook.
Looking for a change of pace or seeking new talent? Search and post 3D Printing Jobs for opportunities and new talent across engineering, marketing, sales and more.
Featured image shows yhe final facial prosthesis created using a 3D printed prototype. Photo via AFP.
Scientists from the Human Genome and Stem Cell Research Center (HUG-CELL) University of São Paulo (USP), have utilized 3D bioprinting to develop functional hepatic organoids, otherwise known as mini-livers.
Made from human blood cells, the mini-livers replicate normal functions such as producing vital proteins, storing vitamins, and secreting bile. Though still leagues away from a full-sized, fully functional organ, the researcher is a fundamental step towards such a challenging goal.
“More stages have yet to be achieved until we obtain a complete organ, but we’re on the right track to highly promising results,” said Mayana Zatz, director of HUG-CELL and last author of the article published in Biofabrication.
“In the very near future, instead of waiting for an organ transplant, it may be possible to take cells from the patient and reprogram them to make a new liver in the laboratory. Another important advantage is zero probability of rejection, given that the cells come from the patient.”
Liver tissue from patient cells
With the CELLINK INKREDIBLE+ 3D bioprinter, the HUG-CELL team used groups of Human-induced pluripotent stem cells (iPS) in a bioink to produce tissue maintaining hepatic (liver) functions. Ernesto Goulart, a postdoctoral fellow in USP’s Institute of Biosciences and first author of the article, stated:
“Instead of printing individualized cells, we developed a method of grouping them before printing. These ‘clumps’ of cells, or spheroids, are what constitute the tissue and maintain its functionality much longer. We started the differentiation process with the cells already grouped together. They were cultured in agitation, and groups formed spontaneously.”
The spheroid formation allowed the team to overcome a common issue in human tissue bioprinting techniques, which involves the gradual loss of contact among cells causing a loss of tissue functionality. According to the study, this occurs in most of the available methods for printing live tissue which use immersion and cell dispersion in a hydrogel to create the necessary microenvironment and tissue functionality.

3D bio-printed mini-livers in 90 days
After producing the 3D bioprinted hepatic tissue, the resulting structures were left to mature in culture for 18 days. The transformed hepatic tissue contained hepatocytes, vascular cells, and mesenchymal cells. Overall, the differentiation, 3D bioprinting, and maturation stages of creating the mini-livers took 90 days. Goulart added:
“Our spheroids worked much better than those obtained from single-cell dispersion. As expected, during maturation, the markers of hepatic function were not reduced. We did it on a small scale, but with investment and interest, it can easily be scaled up.”
The full study is titled, “3D bioprinting of liver spheroids derived from human induced pluripotent stem cells sustain liver function and viability in vitro”. It is co-authored by Ernesto Goulart, Luiz Carlos de Caires-Junior, Kayque Alves Telles-Silva, Bruno Henrique Silva Araujo, Silvana Aparecida Rocco, Mauricio Sforca, Irene Layane de Sousa, Gerson S Kobayashi, Camila Manso Musso, Amanda Faria Assoni, Danyllo Oliveira, Elia Caldini, Silvano Raia, Peter I Lelkes, and Mayana Zatz.
Keep up with the latest 3D printing news by subscribing to the 3D Printing Industry newsletter, follow us on Twitter and like us on Facebook.
Looking for an opportunity in the 3D printing industry? Visit 3D Printing Jobs to commence your career in additive manufacturing.
Featured image shows a visualization of a liver. Image via Shutterstock.
3D Bioprinting Solutions, a Russian bio-technical research laboratory, has 3D bioprinted bone tissue in zero gravity on the International Space Station (ISS).
Executed on the lab’s magnetic 3D bioprinter Organ.Aut, this experimentation is working to enable the creation of bone implants for astronaut transplantation during long-term interplanetary expeditions.

Zero gravity 3D bioprinting
As a subsidiary of Invitro, a private medical company in Russia, the Moscow-based 3D Bioprinting Solutions created the Organ.Aut to study how living organisms are affected by long flights in outer space. Last year, it was delivered to the ISS onboard the Soyuz MS-11 manned spacecraft following a previous failed launch from the Soyuz MS-10 spaceflight.
Earlier this year, the company announced plans to collaborate with scientists from the U.S. and Israel to deliver muscular tissue biomaterials. Following this, its researchers carried out a high molecular weight protein crystallization experiment in zero gravity using a new method dubbed as magnetic sedimentation of protein molecules. Such tests resulted in crystals measuring from 300 to 1500 micrometers.
According to the team, this study could lead to unique protein crystals exclusively produced in space. Ultimately this could aid in the creation of advanced drugs that affect viruses and bacteria at the molecular level.

Advancing medical care for astronauts
Described by 3D Bioprinting Solutions as a first, 3D bioprinted bone tissue was fabricated in space using growing fragments of bone structures. The tissues comprised of calcium phosphate ceramics populated with living cells. This aims to aid ailing astronauts who may experience a decline in health due to bone structure degeneration from extensive exposure to microgravity.
Currently, the researchers have identified a lack of specialized medical care for such maladies. The latest samples are now being studied on Earth to determine their viability for transplantation in the future.

Keep up with the latest 3D printing news by subscribing to the 3D Printing Industry newsletter, follow us on Twitter and like us on Facebook.
Looking for an opportunity in the 3D printing industry? Visit 3D Printing Jobs to commence your career in additive manufacturing.
Featured image shows the magnetic 3D bioprinter known as Organ.Au. Photo via 3D Bioprinting Solutions.
AdventHealth Nicholson Center, a Florida-based medical training facility, has launched its Prototype Lab to enable the development of medical devices using additive manufacturing technology.
As an innovative space for healthcare professionals, the Prototype Lab will provide CAD modeling and 3D printing to develop, test and refine inventions to improve clinical care. Jodi Fails, B.S., Biomedical Engineer, and Prototype Lab lead at AdventHealth Nicholson Center explained:
“Our expert team can help bring an idea from ‘napkin sketch’ to reality, and our 3D printing capabilities allow inventors to hold an actual version of their device in their hands for evaluation.”
“Most product developers assist with creation but have to look externally for lab testing. However, with Nicholson Center’s Prototype Lab, we have the unique ability to take inventions straight from the printer to the lab for immediate testing on high-quality tissue.”

The Prototype Lab
Founded in 2002, AdventHealth Nicholson Center has trained over 50,000 physicians worldwide. For the creation of personalized medical devices, the newly established Prototype Lab aims to take an initial concept and complete a preliminary art and patent. A 3D model is then created and the final design is selected for production on an in-house Objet 350 Connex3 polyjet 3D printer from Stratasys.
The device is subject to immediate testing on tissue, which can also contribute to its validation by the Food and Drug Administration (FDA). Moreover, the lab is developing specialized educational training devices for courses to teach specific procedures.
“Beyond the technology and testing capabilities at Nicholson Center, our experts bring the pivotal industry knowledge that is so crucial to the early stages of product development,” stated Lilly Graziani, Director of Corporate Development at AdventHealth Nicholson Center.
“With a key balance of tradition and innovation, our engineers, physicians and clinical staff work with inventors to create a product that will reach the medical community’s ultimate goal: improving patient outcomes.”

3D printing medical labs
Medical institutes have been leveraging additive manufacturing for pre-surgical guidance and training purposes. Earlier this year, axial3D, a medical manufacturing service provider headquartered in Northern Ireland, is providing Newcastle Hospitals NHS Foundation Trust with an on-site 3D printing lab. Located at the Royal Victoria Infirmary, one of six potential beneficiaries of the facility, the lab will be used to produced patient-specific models for pre-surgical planning.
Want the latest 3D printing news? Subscribe to the 3D Printing Industry newsletter, follow us on Twitter and like us on Facebook.
Looking for a fresh start in the 3D printing industry? Visit 3D Printing Jobs to commence your career in additive manufacturing.
Featured image shows a 3D printed anatomical heart model. Photo via AdventHealth Nicholson Center.
Scottish biomaterial developer, Biogelx, and Regemat 3D, a Spain manufacturer of bioprinting systems, have partnered to develop a new skin model as well as offering complete bioprinting solutions for research institutes worldwide.
“We are excited to see future tissue models using Biogelx-INKs,” said Sandy Bulloch, Director of Strategic Alliances, Biogelx.
“We believe that this strategic partnership will expand the distribution of our novel peptide-based bioink products to new and existing customers worldwide and provide Regemat3D with an extended platform to provide their customers a robust synthetic bioink for use with their very successful range of bioprinters.”

Biogelx and 3D bioprinting
Biogelx spun-out from the Ulijn Group, a company focused on minimalistic molecular materials and adaptive systems at the University of Strathclyde, Glasgow. It has developed self-assembling synthetic peptide products for 3D cell culture supporting regenerative medicines and drug discovery.
Earlier this year, Biogelx released Biogelx-INKs, its first 3D bioprinter ink to the market. As hydrogel-based inks, Biogelx-INKs are designed to be easily printable and exhibit excellent shear-thinning properties, which reduce the stress experienced by cells when subjected to the printing process.
Last month, the company set its sights on the Brazilian medical sector following a partnership with 3D Biotechnology Solutions (3DBS), a startup specializing in custom bioprinter and electrospinning machines.
Regemat 3D accelerates tissue engineering
Regemat 3D was founded in 2011 by Jose Manuel Baena, Ph.D. in Biomedicine from the University of Granada, Spain and MSc Engineering from Polytechnic University of Valencia. The company manufactures both standard and personalized inkjet bioprinters and is presently developing clinical and pre-clinical models from cartilage to living tissues in over 20 countries.
“Regemat 3D is always seeking out the best 3D bioprinting technologies solutions that the researchers need,” stated Manuel Figueruela, CEO of Regemat 3D. “We do believe that this new collaboration with Biogelx will open a new opportunity to offer something new and exciting for researchers to enjoy a true combination of consistency, reproducibility, and value for money.”
“The two brands together offer something new and exciting for researchers to enjoy a true combination of consistency, reproducibility, and value for money. We’re thrilled to be working with Biogelx on this exciting opportunity.”

Subscribe to the 3D Printing Industry newsletter, like us on Facebook and follow us on Twitter for all the latest 3D bioprinting news. Visit 3D Printing Jobs for new opportunities in additive manufacturing.
Featured image show Biogelx-INKs on a Regemat 3D bioprinting system. Photo via Biogelx.
Guyson International, a North Yorkshire-based industrial finishing equipment manufacturer, has launched its Powder Flush system to clean 3D printed medical implant trabecular structures.
Trabecular structures aid in the interlocking of human bone growth at the end of long bones or in the spinal column. Metal additive manufacturing processes such as SLM and EBM have enabled the customization of these implants. Due to its porous nature, particle residue is often present in the 3D printed implants, hence the need for powder flushing.
“Guyson has become the ‘go-to’ company for post-processing finishing equipment in the 3D Printing marketplace,” said Mark Viner, Managing Director of Guyson International. “This new Powder Flush unit adds to the already extensive portfolio of Guyson products provided for the Additive Manufacturing market.”

Post-processing 3D printed medical implants
The Powder Flush is based on Guyson International’s Orbit 600 rotary basket spray wash unit. This system is fitted with a 100-liter insulated tank and hot spray flushing for thorough cleaning purposes. It also offers directed jets for powerful component flushing followed by a compressed air-wash.
As the company’s latest additive manufacturing post-processing system, the Powder Flush integrates a PLC/HMI control panel which provides data monitoring and a timed pre-heat function ensuring accurate and repeatable process operation. Following its production, the 3D printed medical implants are individually or batch loaded on non-contaminating fixtures directed towards the flushing jets.
“[This system joins] our Euroblast Ex range of ATEX certified blast cabinets for surface finishing exotic metal AM parts, often used in the aerospace and medical markets,” added Viner.
“[Furthermore,] the Guyson PRS (Powder Recovery System), which is an automated post-processing system, specifically for EBM additive builds, uses tried and trusted robotic blasting methodology to reveal components and manage the resultant powder in a highly contained blast system, and our ‘Kerry’ branded range of ultrasonic baths and tanks for 3D printed FDM support removal.”

Guyson and Materials Solutions
Earlier this year, Guyson International, installed four Euroblast blasting machines in the Digital Factory of Materials Solutions, a Siemens business specializing in 3D printing. As an SLS post-processing system, Euroblast is used to removes unsintered particles from 3D printed parts.
“Materials Solutions has been using Guyson blasters since our origin and when it came to upgrade and update it made perfect sense to us to go back to Guyson,” explained Phil Hatherley, General Manager at Materials Solutions. “We have increased size capability plus capacity and working with our team Guyson has provided us with a quality solution for blasting the larger components that our customers are now looking for us to supply.”
For more additive manufacturing news, subscribe to our 3D Printing Industry newsletter and join us on Facebook and Twitter.
We also have jobs in the industry, visit our 3D Printing Jobs page to learn more.
Featured image shows the Orbit 600 Special Powder Flush system for removal of residual additive manufacturing powders from trabecular structures. Photo via Guyson International.
B9Creations, the South Dakota-based manufacturer of the B9 Core Series of DLP 3D Printers, has launched a new additive manufacturing Healthcare Division & Service Bureau as well as a 3D printer targeted at the medical industry.
The B9 Core Med 500, released with the first two of the company’s suite of biocompatible materials, will support the new division which aims to develop new medical devices, anatomical models, surgical tools, and wearable technology.

B9Creations and medical 3D printing
Earlier this year, B9Creations partnered with SDC Technologies, California-based coating specialists, to open a $500,000 additive manufacturing materials development lab. This lab is located at B9Creations’ Rapid City headquarters. Now, the Healthcare Division & Service Bureau will further facilitate a diverse portfolio of medical applications.
The company’s 3D printers have been used for dental and medical models. This includes surgical tools and instrumentation, training models, customized lab and manufacturing tools, jigs as well as fixtures for enhanced productivity.
It states that its technology serves nearly 70 countries worldwide, with brands from Proctor & Gamble, 3M, B. Braun Medical Inc., Kulzer, and the National Institutes of Health (NIH).

B9 Core Med 500
The B9 Core Med 500 has been designed to be four times faster than other systems in the market, include factory startup assistance, and eliminate calibration. It is accompanied by biocompatible and engineering materials. The 3D printer is currently priced at $11,955.
| Technical Specifications | |
| Print Dimensions | 103 x 58 x 130 mm |
| Weight | 21kg (46 lbs) |
| Machine Dimensions | 267 x 420 x 593 mm |
| Print Speeds | 15-120+ mm/hr |
| Resolution | 53.6 µm |
| Light Source | Industrial HD UV LED Light Engine – 405nm |
| Material System | B9Creations Resins & 3rd Party Materials |
| Software | B9Create |
| Power | 12VDC 5A |
For more medical 3D printing news, subscribe to the 3D Printing Industry Newsletter and join us on Facebook and Twitter. Looking for a job in the industry? Visit 3D Printing Jobs for new vacancies.
Featured image shows B9 Core Med 500 additive manufacturing Healthcare Division & Service Bureau. Photo via B9Creations.